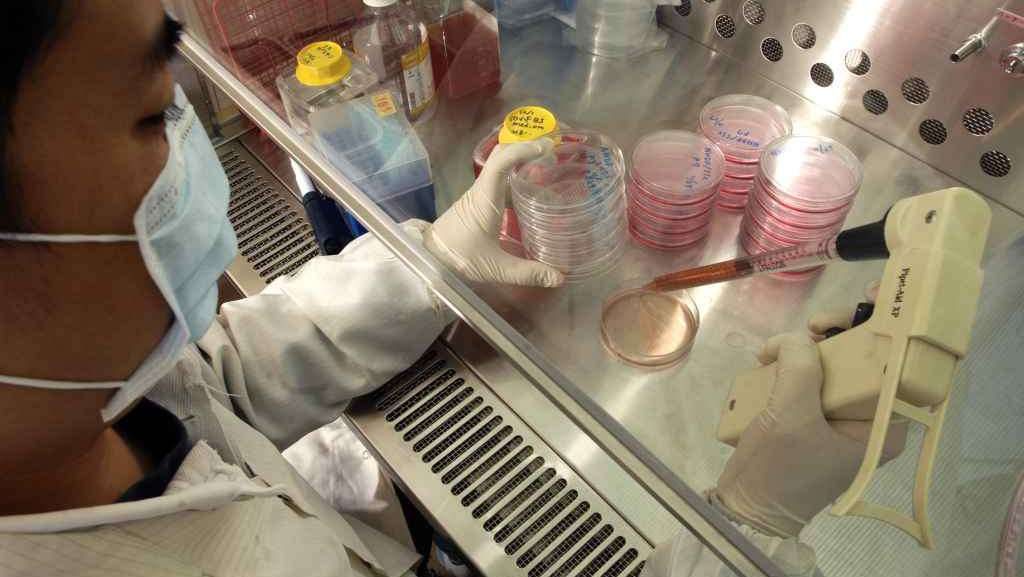

ROMA — All’inizio fu Dolly. La nascita della prima pecora clonata attraverso una tecnica capace di riprogrammare cellule adulte, dimostrò ai ricercatori che era possibile ottenere staminali indifferenziate, cioè capaci di trasformarsi in ogni tessuto, senza la necessità di utilizzare l’embrione. Succedeva sedici anni fa e col passare del tempo si sono spenti gli entusiasmi degli scienziati di servirsi dello stesso sistema per ottenere staminali umane e immaginare di avere a disposizione una fonte inesauribile di «farmaco» per curare malattie degenerative. Ian Wilmut, che aveva coordinato al Roslin Institute di Edimburgo il lavoro su Dolly, ha in più occasioni affermato: «Con i primati lo stesso metodo non funziona. Non sappiamo perché. I risultati non sono quelli sperati. Per fortuna ci sono tecniche alternative che lasciano sperare in un futuro più roseo». Sembrava una approccio superato, quello di Wilmut. Invece pare riaprirsi una nuova strada. In un articolo pubblicato sulla rivista Cell di ieri un gruppo di ricercatori dell’Università dell’Oregon diretto da Shoukhrat Mitalipov ha annunciato di aver tagliato un traguardo inseguito a lungo. Cellule della pelle sono state riportate indietro fino allo stadio di cellule embrionali. Quelle che sono all’origine di ogni parte del nostro corpo. Le chiamano bambine. Secondo molti commentatori internazionali si è riacceso il sogno della clonazione terapeutica che consente di produrre riserve di cellule riparatrici di singoli pazienti. Parkinson, sclerosi multipla, lesioni spinali. Molte malattie oggi senza soluzione potrebbero essere trattate. E si riaccende anche la miccia delle polemiche. La clonazione, sia pur ottenuta senza la distruzione di embrioni, suscita sempre timori di esperimenti spregiudicati e di prospettive eticamente discutibili. In questo caso il nucleo di una cellula di pelle è stato trasferito in un ovocita a sua volta svuotato del nucleo che contiene il Dna. Grazie alle informazioni provenienti dall’interno dell’uovo, la cellula è tornata indietro nello sviluppo fino ad assumere le caratteristiche primordiali. Secondo Mitalipov «queste staminali sono capaci di trasformarsi in ogni tipo di tessuto come le embrionali, dando origine a tessuti di cervello, fegato o cuore». Sarebbero inoltre stati risolti i problemi di rigetto perché all’origine di questa sorgente ci sono le cellule della persona da curare. Il ricercatore ha però ammesso che «c’è ancora molto da fare prima di arrivare a cure sicure ed efficaci basate su questa tecnica. Riteniamo in ogni modo il nostro lavoro molto significativo per il progresso della medicina rigenerativa». Commenta senza eccessivo ottimismo la notizia, lanciata con grande risalto dai maggiori media internazionali, Giulio Cossu, oggi all’University College di Londra: «A me sembra un avanzamento tecnico che non rivoluziona le attuali conoscenze. Lo stesso protocollo servì per creare Dolly nel ’97. Qui però si tratta dell’uomo. A mio giudizio è un metodo più costoso e complicato rispetto a quello messo a punto nel 2006 da Shinya Yamanaka al quale Io scorso anno è stato assegnato il premio Nobel proprio per queste ricerche». Lo scienziato giapponese ha utilizzato una cellula adulta nella quale ha inserito quattro fattori di trascrizione propri dell’embrione ed ha ottenuto la riprogrammazione, il ritorno allo stato originale. Giuseppe Novelli, genetista dell’università di Tor Vergata, giudica al contrario innovativo il lavoro apparso su Cell: «II protocollo è originale. L’aggiunta di due sostanze rende stabili le staminali a differenza di quelle di Yamanaka la cui riprogrammazione non è completa».

L’Associazione Luca Coscioni è una associazione no profit di promozione sociale. Tra le sue priorità vi sono l’affermazione delle libertà civili e i diritti umani, in particolare quello alla scienza, l’assistenza personale autogestita, l’abbattimento della barriere architettoniche, le scelte di fine vita, la legalizzazione dell’eutanasia, l’accesso ai cannabinoidi medici e il monitoraggio mondiale di leggi e politiche in materia di scienza e auto-determinazione.